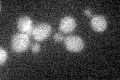
YER014W
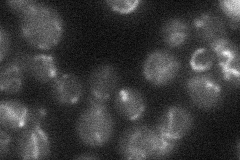
YER014W
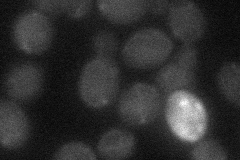
YER014W
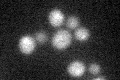
YER014W

View description
Protoporphyrinogen oxidase, a mitochondrial enzyme that catalyzes the seventh step in the heme biosynthetic pathway, converting protoporphyrinogen IX to protoporphyrin IX; inhibited by diphenyl ether-type herbicides
Localization:
Intensity:
Fold change:
Significance:
-
C’ GFP library in SD
below threshold15.98 -
N' NOP1pr-GFP in SD

mitochondria72.8822 -
N' TEF2pr-mCherry in SD

cytosol,mitochondria107.828 -
N' NATIVEpr-GFP in SD
mitochondria20.248 -
N' TEF2pr-VC and Cyto-VN in SD
below threshold23.645 -
C’ GFP library in SD+DTT
cytosol14.280.89No -
C’ GFP library in SD+H2O2

cytosol15.550.97No -
C’ GFP library in Starvation Media

cytosol16.461.02No -
C’ GFP library on the background of Pup2-DaMP

below threshold -
C’ GFP library on the background of CCT mutant

below threshold14.74660.922063No
